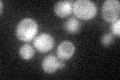
YDL230W
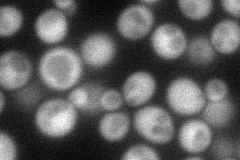
YDL230W
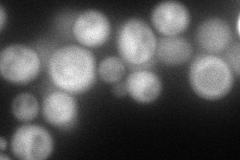
YDL230W
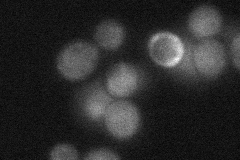
YDL230W
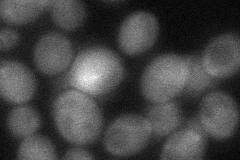
YDL230W
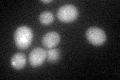
YDL230W

View description
Phosphotyrosine-specific protein phosphatase that dephosphorylates a broad range of substrates in vivo, including Fpr3p; localized to the cytoplasm and the mitochondria
Localization:
Intensity:
Fold change:
Significance:
-
C’ GFP library in SD
cytosol26.9 -
N' NOP1pr-GFP in SD
cytosol67.8195 -
N' TEF2pr-mCherry in SD
cytosol86.7747 -
N' NATIVEpr-GFP in SD
cytosol29.3881 -
N' TEF2pr-VC and Cyto-VN in SD
cytosol42.0581 -
C’ GFP library in SD+DTT
cytosol28.491.05No -
C’ GFP library in SD+H2O2

cytosol23.720.88No -
C’ GFP library in Starvation Media

cytosol29.411.09No -
C’ GFP library on the background of Pup2-DaMP

cytosol -
C’ GFP library on the background of CCT mutant

cytosol27.01931.00405No
